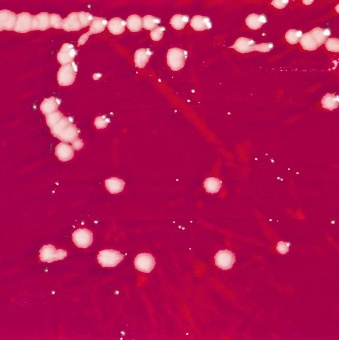
4617-314463-2.jpg

Ministrul dezvoltării Elena Udrea a anunţat că anul viitor vor fi înfiinţate 400 de creşe, specialiştii instituţiei estimând că vor fi necesari cam 100.000 de euro pe unitate. Jumătate dintre creşe vor fi amenajate în clădirile unor spitale mici, în care de zeci de ani nu s-a mai făcut nici o investiţie şi unde bacteriile şi virusurile colcăie în pereţi. 
“Ministerul Sănătăţii trebuie să închidă 200 de spitale mici, fără dotare, în care omul nu are nici o şansă aproape”, a explicat, la rândul lui, preşedintele Traian Băsescu, adăugând că aceste imobile sunt ideale pentru creşe şi aziluri de bătrâni. Şeful statului uită însă că în aceste spitale pacienţii vin cu o fractură şi pleacă în sicriu, după ce rana li se infectează. S-a întâmplat la Slatina, unde nu s-a putut stabili cum un copil cu mâna ruptă a făcut septicemie şi a decedat sub ochii medicilor.
Clădirile sunt focare de infecţie
În urmă cu nouă luni Libertatea a dezvăluit faptul că o mulţime de virusuri şi de bacterii rezistă în pereţii instituţiilor chiar după ce acestea sunt renovate, singura soluţie pentru a face să dispară aceste focare de infecţie fiind demolarea completă a clădirilor. Aşa că soluţia propusă de preşedintele Băsescu nu e una tocmai nimerită având în vedere pericolul la care vor fi expuşi bebeluşii.

Gravidele îşi grăbesc naşterea
De luna viitoare, toate femeile care nasc vor primi indemnizaţie doar 12 luni. Pentru a putea beneficia de concediu maternal plătit timp de doi ani, multe gravide s-au programat să nască mai devreme, prin cezariană, chiar dacă acest lucru le poate pune în pericol viaţa.
Maria Băsescu a avut concediu maternal de trei luni
După ce în ultimele săptămâni s-au vehiculat mai multe variante de acordare a acestui tip de ajutor social, sute de mămici şi-au exprimat nemulţumirea chiar în stradă. Enervat de revoltele acestora, Traian Băsescu a spus, miercuri seara, la o emisiune difuzată de televiziunea publică: “În ultima vreme, România a devenit o ţară de mămicuţe şi bebeluşi. Sunt femei care trebuie să aibă şansa reintegrării sociale după naştere”. Pentru a aduce argumente, preşedintele a dat-o exemplu pe soţia sa, Maria, care lucra ca recepţionară la un hotel din Constanţa şi s-ar fi întors la serviciu după trei luni de la naşterea copilului.
Iată ce bacterii colcăie în pereţii saloanelor
Escherichia Coli (E. Coli)
Escherichia Coli e rezistentă la multe antibiotice şi este responsabilă pentru un număr mare de infecţii urinare şi diges- tive.
Pseudomonas Aeruginosa (Piocianic)
Pseudomonas Aeruginosa e responsabilă de grave infecţii la pacienţii cu imunitate scăzută. Este cunoscută şi sub denumirea de bacil piocianic.
Acinetobacter
Acinetobacter este întâlnit frecvent în secţiile de Terapie Intensivă. Poate provoca infecţii fatale, pentru că e rezistent la multe antibiotice.
Klebsiella
Este o bacterie cu o rezistenţă crescută la antibiotice şi care atacă sistemul respirator, digestiv şi cel genito-urinar.
:contrast(8):quality(75)/https://www.libertatea.ro/wp-content/uploads/feed/images/280_8479fe165f87f7722447cf1b142c311a.jpg)
:contrast(8):quality(75)/https://www.libertatea.ro/wp-content/uploads/feed/images/280_47bf299ee9de600b7e129bf8ad4a69d5.jpg)
:contrast(8):quality(75)/https://www.libertatea.ro/wp-content/uploads/feed/images/280_fbf2e1f53f86a5eb6dcf2670fda53e9f.jpg)
:contrast(8):quality(75)/https://www.libertatea.ro/wp-content/uploads/feed/images/280_197fe75819556e3868ebc7343afa365b.jpg)
:contrast(8):quality(75)/https://www.libertatea.ro/wp-content/uploads/feed/images/280_408ac315d671c3e4d84c90ab69689d8a.jpg)
:quality(75)/https://www.libertatea.ro/wp-content/uploads/feed/images/280_a21941d9659379b89ef65453ed0a1558.png)
:quality(75)/https://www.libertatea.ro/wp-content/uploads/feed/images/276_287988ff1ff78cb6d53eb15e4164e11f.png)
:contrast(8):quality(75)/https://www.libertatea.ro/wp-content/uploads/feed/images/206_a85211a192935980208faa94d025dc3b.jpg)
:contrast(8):quality(75)/https://www.libertatea.ro/wp-content/uploads/feed/images/278_db78c329f4a2586a9d024802acb2c4f0.webp)
:contrast(8):quality(75)/https://www.libertatea.ro/wp-content/uploads/feed/images/50_b17e8872e571b99f0daf1d62017df8b4.jpg)
:contrast(8):quality(75)/https://www.libertatea.ro/wp-content/uploads/feed/images/281_d349925b10067b61941cc3defe23877d.jpg)
:contrast(8):quality(75)/https://www.libertatea.ro/wp-content/uploads/feed/images/153_d2b40979f3bf29e9025e5094d59f78d8.jpg)
:contrast(8):quality(75)/https://www.libertatea.ro/wp-content/uploads/feed/images/233_3a70273b8a9391c09024d47bbeaea7bb.jpg)
:contrast(8):quality(75)/https://www.libertatea.ro/wp-content/uploads/feed/images/253_82a075d8ba0857f9a096c392fffe62ef.jpg)
:contrast(8):quality(75)/https://www.libertatea.ro/wp-content/uploads/feed/images/197_d6d2e0509d6a025a8f9cdc47ae355ce7.jpg)
:contrast(8):quality(75)/https://www.libertatea.ro/wp-content/uploads/feed/images/284_1349dc8e43280806f9378bb895578f11.jpg)
:contrast(8):quality(75)/https://www.libertatea.ro/wp-content/uploads/feed/images/275_2986dde1b55e0e0f2be0384fc56aeeec.jpg)
:contrast(8):quality(75)/https://www.libertatea.ro/wp-content/uploads/feed/images/274_00a4d63c022554259109b3db66eaec52.jpg)
:contrast(8):quality(75)/https://www.libertatea.ro/wp-content/uploads/feed/images/274_33e34781cf7030bcab03e5f3de2fd9a9.jpg)
:contrast(8):quality(75)/https://www.libertatea.ro/wp-content/uploads/feed/images/288_d1915f58dc2d251018e3d7238da74b37.jpg)
:contrast(8):quality(75)/https://www.libertatea.ro/wp-content/uploads/feed/images/16_216d285b812a1ee70d3b95f511d6b9d3.jpg)
:quality(75)/https://www.libertatea.ro/wp-content/uploads/feed/images/289_f44a5ce4ff819b480e9e6a5794426eeb.png)
:contrast(8):quality(75)/https://www.libertatea.ro/wp-content/uploads/feed/images/206_d07d2dc0f913bbb57a6823d6fad03a25.jpg)
:contrast(8):quality(75)/https://www.libertatea.ro/wp-content/uploads/feed/images/255_014c4e26000ee206c4f6ebd037ceda64.webp)
:contrast(8):quality(75)/https://www.libertatea.ro/wp-content/uploads/feed/images/204_82ce1f1065076da467abaa491c39f04e.jpg)
:quality(75)/https://www.libertatea.ro/wp-content/uploads/feed/images/204_e38817767d9fdcd736b39dba7aa8e98b.png)
:contrast(8):quality(75)/https://static4.libertatea.ro/wp-content/uploads/2026/06/adrian-vestea-inquam-photos-george-calin.jpg)
:contrast(8):quality(75)/https://static4.libertatea.ro/wp-content/uploads/2025/12/traian-basescu-1.jpg)
:contrast(8):quality(75)/https://static4.libertatea.ro/wp-content/uploads/2026/06/shirley-maclaine-tanara.jpg)
:contrast(8):quality(75)/https://static4.libertatea.ro/wp-content/uploads/2026/06/laurette.jpg)
:contrast(8):quality(75)/https://www.libertatea.ro/wp-content/uploads/feed/images/172_25eda6739c0df8617cf17a94f9041a81.jpg)
:contrast(8):quality(75)/https://www.libertatea.ro/wp-content/uploads/feed/images/172_31b0231f353b14bd7223bc62dfca20f3.jpg)
:contrast(8):quality(75)/https://www.libertatea.ro/wp-content/uploads/feed/images/179_cfce57937acd0aa89e315f633cf90084.jpg)
:contrast(8):quality(75)/https://www.libertatea.ro/wp-content/uploads/feed/images/179_9dfe2851dd964ceeeefefbba4bb90fb3.jpg)
:contrast(8):quality(75)/https://static4.libertatea.ro/wp-content/uploads/2026/06/croaziera-dunare-budapesta-ungaria.jpg)
:contrast(8):quality(75)/https://static4.libertatea.ro/wp-content/uploads/2026/06/horoscop-20-iunie-2026.jpg)
:contrast(8):quality(75)/https://static4.libertatea.ro/wp-content/uploads/2026/06/harghita-orheiul-secuiesc.jpg)
:quality(75)/https://static4.libertatea.ro/wp-content/uploads/2026/04/venetia-italia.png)
:contrast(8):quality(75)/https://static4.libertatea.ro/wp-content/uploads/2026/06/peste.jpg)
:contrast(8):quality(75)/https://static4.libertatea.ro/wp-content/uploads/2026/06/telecomanda-aer-conditionat.jpg)
:contrast(8):quality(75)/https://static4.libertatea.ro/wp-content/uploads/2026/06/femeie-machiaj-oglinda.jpg)
:contrast(8):quality(75)/https://static4.libertatea.ro/wp-content/uploads/2026/06/locuitori-zone-albastre-obiceiuri.jpg)
:contrast(8):quality(75)/https://static4.libertatea.ro/wp-content/uploads/2026/06/cheloo.jpg)
:contrast(8):quality(75)/https://static4.libertatea.ro/wp-content/uploads/2026/06/denise-rifai-dna.jpg)
:contrast(8):quality(75)/https://static4.libertatea.ro/wp-content/uploads/2026/06/protest-1-2.jpg)
:contrast(8):quality(75)/https://static4.libertatea.ro/wp-content/uploads/2026/06/colaj-fritz.jpg)
:contrast(8):quality(75)/https://static4.libertatea.ro/wp-content/uploads/2026/06/vestea-bolojan-foto-inquam-photos-madalina-norocea.jpg)
:contrast(8):quality(75)/https://static4.libertatea.ro/wp-content/uploads/2026/06/nicusor-dan-criticat-presa-ucraina-e1780382074205.jpg)
:contrast(8):quality(75)/https://static4.libertatea.ro/wp-content/uploads/2026/06/adrian-vestea-inainte-de-bpn-foto-vlad-chirea.jpg)
:contrast(8):quality(75)/https://static4.libertatea.ro/wp-content/uploads/2026/06/adrian-vestea-9.jpg)
Loghează-te în contul tău pentru a adăuga comentarii și a te alătura dialogului.